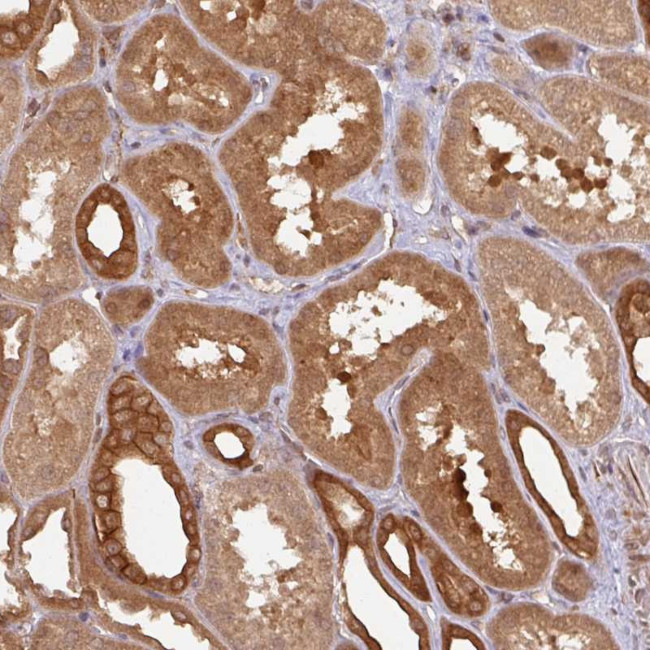
4E-BP2 Antibody in Immunohistochemistry (Paraffin) (IHC (P))

Search
Invitrogen
4E-BP2 Polyclonal Antibody
{{$productOrderCtrl.translations['antibody.pdp.commerceCard.promotion.promotions']}}
{{$productOrderCtrl.translations['antibody.pdp.commerceCard.promotion.viewpromo']}}
{{$productOrderCtrl.translations['antibody.pdp.commerceCard.promotion.promocode']}}: {{promo.promoCode}} {{promo.promoTitle}} {{promo.promoDescription}}. {{$productOrderCtrl.translations['antibody.pdp.commerceCard.promotion.learnmore']}}
产品信息
PA5-57941
种属反应
宿主/亚型
分类
类型
抗原
偶联物
形式
浓度
规格
纯化类型
保存液
内含物
保存条件
运输条件
RRID
产品详细信息
Immunogen sequence: VTSPGTLIED SKVEVNNLNN LNNHDRKHAV GDDAQ
Highest antigen sequence identity to the following orthologs: Mouse - 94%, Rat - 91%.
靶标信息
PHAS-II (eIF4E-binding protein II) is involved in translation initiation. PHAS-II is highest in liver and kidney. PHAS proteins bind to eIF-4E, the mRNA cap-binding protein, and inhibit translation of capped mRNA in vitro and in cells. Phosphorylation in the appropriate site(s) promotes dissociation of PHAS/eIF-4E complexes. This allows eIF-4E to bind to eIF-4G (p220), thereby increasing the amount of the eIF-4F complex and the rate of translation initiation. Pharmacological and genetic evidence indicates that the mTOR/p70S6K pathway is involved in the control of PHAS-I and -II. Thus, PHAS proteins may be mediators of the effects of this pathway on protein synthesis and cell proliferation.
仅用于科研。不用于诊断过程。未经明确授权不得转售。
篇参考文献 (0)
生物信息学
蛋白别名: 4E-BP2; eIF4E-binding protein 2; EIF4EBP2; Eukaryotic translation initiation factor 4E-binding protein 2; phosphorylated, heat and acid stable regulated by insulin protein II; unnamed protein product
基因别名: 4EBP2; EIF4EBP2; PHASII
UniProt ID: (Human) Q13542
Entrez Gene ID: (Human) 1979